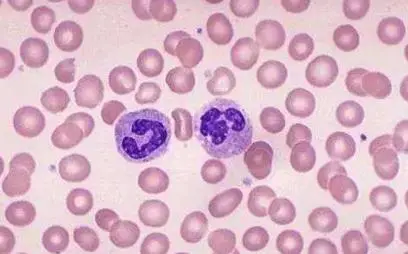

佰草通源:为啥一到医院就要抽血?医生揭秘:抽出来的血,最终去了哪里.
当身体在感觉不太舒服时,大家都会去医院进行相关的健康体检。
而这个时候医生也会开具相关的检查单,当然绝大多数人都或许有了解过,那就是进行检查时有一个项目是必做的,也就是抽血检查。
血常规以及尿常规是临床当中特别常见的一种检查项目,但是很多人都特别怀疑,为何一到医院就会需要抽血呢?
有的时候还会一抽好几管,那么这些抽出来的血最终又都会送去哪里呢?今天就带大家一一了解清楚。

为啥一到医院就要抽血?
如果身体某些器官或系统出现异常,不管是外来入侵引起还是内部失衡诱发,一般会体现在血液指标浮动上,检查血液就能看出来。
血液就像汽车的汽油和机油,没有汽油跑不了,没有机油走不远。如果汽车因各种原因出问题,油液是必查环节。所以说诊断病症,血液有很突出的指导意义。
而且,从性价比看,医院众多的检查项目和方案,指标最全、覆盖面最大、时间相对较短、费用相对较少的,就是血液检查。

抽血能检查出癌症吗?
验血通常并不能够完全确认癌症。验血化验主要是能够检查血常规、肝功能、肾功能以及相关的肿瘤标志物检查,能够发现肿瘤患者出现贫血、低蛋白血症以及肿瘤标志物的变化。例如癌胚抗原、甲胎蛋白、CA199等。
但以上肿瘤标志物的改变,并不能够完全确认癌症的存在。只是提示有癌症的可能性,临床参考性的意见或指标,仍然需要进一步的检查确认。

抽血能查出什么病?专家:四类疾病可被轻易筛查
1.上呼吸道感染疾病
抽一管血,就能知道,究竟是细菌感染,还是病毒感染。一般情况下,如果是细菌感染,白细胞的数量就会迅速升高,中性粒细胞也会升高。
慢性阻塞性肺病、支气管扩张、哮喘的病人由于上呼吸道感染会导致病情急性加重,要根据医生安排上调剂量,做相应的药物调整。
值得注意的是,上呼吸道感染的药物治疗只能缓解症状,主张患者少用药,等疾病的自限期过了,症状便会缓解。

2.脏器功能
通过检查胆红素、转氨酶、肌酐和尿素氮等来查看是否存在肝肾功能异常;检查血脂、甘油三酯、胆固醇、高密度脂蛋白和低密度脂蛋白是否存在异常,来发现是否患有代谢性疾病,也是诊断高血脂症的依据。

3.高血糖
空腹8小时抽测的血糖值高于正常值4.0-6.1mmol/L的标准,即可被认为是高血糖症。或餐后两小时血糖测定值超出7.8mmol/L,也可以称为高血糖,高血糖并不完全等于糖尿病。

4.心血管以及脑血管疾病
能否及时发现心血管以及脑血管疾病在一定程度上影响了患者的生命。验血检查不但可以检查血脂、血糖等常规项目,更可以检查心肌酶,提早发现患者是否有心血管疾病或是脑血管疾病。

5.血液系统疾病
通过血常规检查,可以计算红细胞的数量,观察红细胞的形状和大小,从而了解有没有贫血,贫血的程度,有没有缺铁。
还可以计算白细胞数量,判断有没有感染,感染的严重程度,有没有白血病等等。通过血小板的计数,可以判断有没有血小板减少,有没有出血倾向。
医生揭秘:抽出来的血,最终去了哪里?
临床上将病人抽出来的血液都默认为潜在污染源,一般会将这些样本留存7天左右,以备有时候需要复查。
在7天后,血液样本会被检验科以高压消毒、化学方法灭菌后跟随其他的医疗废物进行统一的无害化处理。
去医院就诊,要求做血液检查是非常有必要的,大家对此要持有正确的心态,不必过分抗拒。

抽血前后需要注意什么?
1.空腹时采集血的时间
一般抽血之前都是早晨,而且早餐是不能吃的,距离前一天进食8到12个小时左右的时间抽的血。
因为吃完饭之后,血液中一些物质会有一些很大的变化,这样不能真实的反应身体的真实情况,而且验血之前饮食要清淡,这样才更好。

2.采血前不宜多运动
静态运动,虽然持续时间不长,但具有高强度,如举重、扔球等,利用肌肉内储存的能量进行,对化验影响不大。
另一类运动是动态的,即持续时间长,动作强度不大。如长跑、游泳、自行车比赛等,需要大量热量才能维持,对化验结果影响较大,在化验前2天内要尽量避免。

3.调整饮食
建议在抽血前一天要注意清淡饮食,不要吃油腻、含糖量高、辛辣的食物,比如炸鸡、巧克力、辣条等。
也不建议饮酒、喝咖啡等,以免影响到检查结果,并且要注意配合医生进食8-12小时,如果不了解具体时间,可以提前进行咨询。

4.放松心情
很多人从小到大都是害怕打针或者害怕抽血的,在检查的过程中如果情绪过于紧张和焦虑,都可能会导致血压增高的现象,可能会导致内分泌紊乱影响的检查结果。

延伸阅读:献血多久可以献一次?
按照我国献血法规定,健康公民献血的时间不应短于半年。
因为献血时献血量在300-400ml之间,人体会损失部分血细胞,其中包括红细胞、白细胞、血小板等。
水分、白细胞、电解质等恢复的较快,而红细胞恢复的时间较慢,往往需要3-4个月的时间才能恢复至献血前的水平,因此6个月左右的时间才可以献血一次。

总而言之,大家不用去害怕抽血,或者是怀疑抽血的用途。为了自己的健康着想,希望大家还是多多了解血液方面的知识,积极配合医护人员的抽血工作。只有这样,才能够更准确地了解到自己的身体情况。
最后问一下,大家有没有过抽血的经历呢?给你留下了哪些深刻的印象呢?欢迎留言分享!

